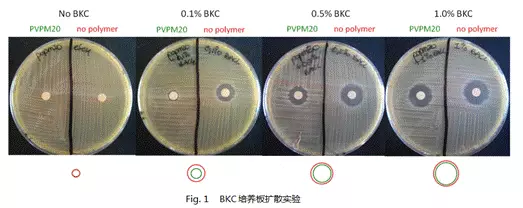
1 90d76

导读:知道吗,据WHO统计,标准的手部清洁和消毒,每年能救100万人的命呢!
院内感染不是啥新鲜事,每个医院都经历过,凶残起来,两三天带走七八条人命也不是没有的。近期,《Nature》上的一篇文章点出,大部分院感是由医护与患者直接接触导致的病菌传播,文章还强调,手部的直接接触是重点传播途径,而且啊——被感染的不止有患者,医护也有中招的!因此,手部清洁,在遏制院感上大有可为哦。
给手消毒,也没那么容易呢
知道吗,据WHO统计,标准的手部清洁和消毒,每年能救100万人的命呢!
可是,这种“标准的清洁消毒”在实际中是很难达到的。因为,首先,它要求医护人员在接触不同病人之间进行常规的手部消毒。不提消毒内容,光是接触每位患者都要重新消毒就足够忙碌的医护们喝一壶了。其次,这种方式本身也有风险——其中一个关键的问题就是常规的严格消毒要求医护人员使用肥皂、乙醇或者氯己定类的消毒剂反复洗手,而反复洗手会造成医护人员手部的不适,过度洗手也会破坏他们的手部皮肤,有利于各种细菌的定植进而导致病原菌更容易传播。
另一个替代方案则是戴手套,可实际上日常的查体、问询中的接触和一些常规的小操作中医护未必有时间和意识来戴上手套,比如在查房时检查患者巩膜颜色,这样一个较小的动作,很难想到要去戴手套或洗完手再来。
因此,研究人员一直在搜寻更好的方案来改良甚至替代常规的防护手段, 最近,一款新型武器浮出水面——“抗菌微手套”。
“抗菌微手套”的小历史
其实,仅仅说“抗菌微手套”这一概念,它可不新了——不仅不新,还比现在的所有医护都老呢。早在1899年,连外科手套都没普及的时候,德国医生Carl Ludwig Schleich就想出使用蜡胶覆盖在手上的方式,用于外科医生的手部与患者隔离,他管这叫“显微手套”,说是可以“防水、防血、防菌”。比较遗憾的是,这方法不怎么好使,不仅持久度有问题,还影响医生的手部触感。
但是,这个概念还挺有生命力的,因为到1943年,来自芝加哥大学的一伙外科医生又报告:阳离子阻滞剂也好用啊!不过他们可不是让医生的手除菌,而是把细菌隔离在医生的手上——他们的报告中称,阳离子阻滞剂能在手上形成一层看不见的薄膜,把细菌保留在膜下,这样接触患者的那一面就无菌啦!……还真是一伙无私的人啊。
最新款式,把前辈们的缺点都克服了!
近期,《Nature》上发布了一款以手凝胶为形式的抗菌微手套。其采用了聚乙烯吡咯烷酮(PVP)为基础,并将之与马来酸盐衍生物M20一起应用以改善其成膜的能力和质地,这样就可以形成一层轻薄又舒适的高分子聚合膜。为了增强微手套的抗菌能力,研究人员还在上述联合物中使用了苯扎氯铵(BKC)这种普遍应用的阳离子表面活性剂和相转移催化剂。
也就是说,既有隔离效果,又有杀菌作用,还不影响手部触感——把前辈们的缺点都克服了!
让我们来直观看看抗菌效果吧!以下是不同配比的微手套原料针对金色葡萄球菌的培养效果,第四盘,有1.0%BKC成分的抗菌环是最大的,也是最终被采纳的配方。
确定最佳配方后,试验人员进行了双盲对照试验,给两组人分别使用了普通凝胶和抗菌微手套凝胶,然后让他们日常活动(不能洗手和消毒),3小时后让他们将手轻轻接触培养基以此来检测微手套的抗菌能力。结果如下图,使用微手套的志愿者的细菌菌落平均值不到对照组的一半,有的甚至暴减40倍!

如此看来,这最新一代的抗菌微手套,立即除菌的同时能缓慢的释放BKC,从而抑菌更持久(超过3小时),与现存的免洗搓手液比有明显优势,因为普通的免洗搓手液原则上与洗手类似,应该在接触每名患者前后都使用。看来,这种凝胶形式的微手套,可以避免大家反复洗手或搓手的麻烦,也能有效阻止细菌的院内传播。
更好消息是——院方可以自己配制这种手套!研究人员非常无私地公布了配方:PVPM20-80:20 0.9%BKC。同志们赶紧配起来,院方自己配的,可比拆开了就进入保质倒计时的商业品更有效!
当然,并不是说大家戴上微手套就一劳永逸啦,毕竟还有那么多预防细菌感染的措施呢,联合作战才有前途~
参考文献
Ciccolini, M., Donker, T., Grundmann, H., Bonten, M. J. & Woolhouse, M. Efficient surveillance for healthcare-associated infections spreading between hospitals. Proc. Natl. Acad. Sci. USA 111, 2271–2276 (2014).
Ciccolini, M. et al. Infection prevention in a connected world: The case for a regional approach. Int. J. Med. Microbiol. 303, 380–387 (2013).
Pittet, D. Compliance with hand disinfection and its impact on hospital-acquired infections. J. Hosp. Infect. 48, 40–46 (2001).
Reilman1, E., Hagting, J.G., Flipsen, T., et al. Towards an antimicrobial‘microglove’. Published on line www.nature.com/scientificreports Scientific RepoRts | 5:16679 | DOI: 10.1038/srep16679
Why were surgical gloves not used earlier?DOI: http://dx.doi.org/10.1016/S0140-6736(15)00271-8
作者: 二刀 潘达君
